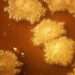
Kanser tedavisinde biyolojik devrim: Tümörü içeriden yok eden ‘akıllı’ bakteriler geliştirildi

Epic Games, 12 Mart’a kadar Turnip Boy Robs a Bank ve Idle Champions of the Forgotten Realms hediye paketini ücretsiz olarak kütüphaneye eklemeye imkan tanıyor. Epic Games hesabı olan kişiler belirlenen tarihe kadar içerikleri ücretsiz bir şekilde oyun kütüphanelerine ekleyebiliyor.
Turnip Boy Robs a Bank, komedi türünde bir aksiyon, macera roguelite oyunu olarak konumlandırılıyor.
Idle Champions of the Forgotten Realms hediye paketinin içinde ise Raistlin Majere, Gale, Spurt, Briv ve Ellywick karakterleri, her karakter için 32 Platin Sandık, iki haftalık iksir ve özel bir Baaz Draconian yoldaşı bulunuyor.
***Mutluluk, adalet, özgürlük, hukuk, insanlık ve sevgi paylaştıkça artar***